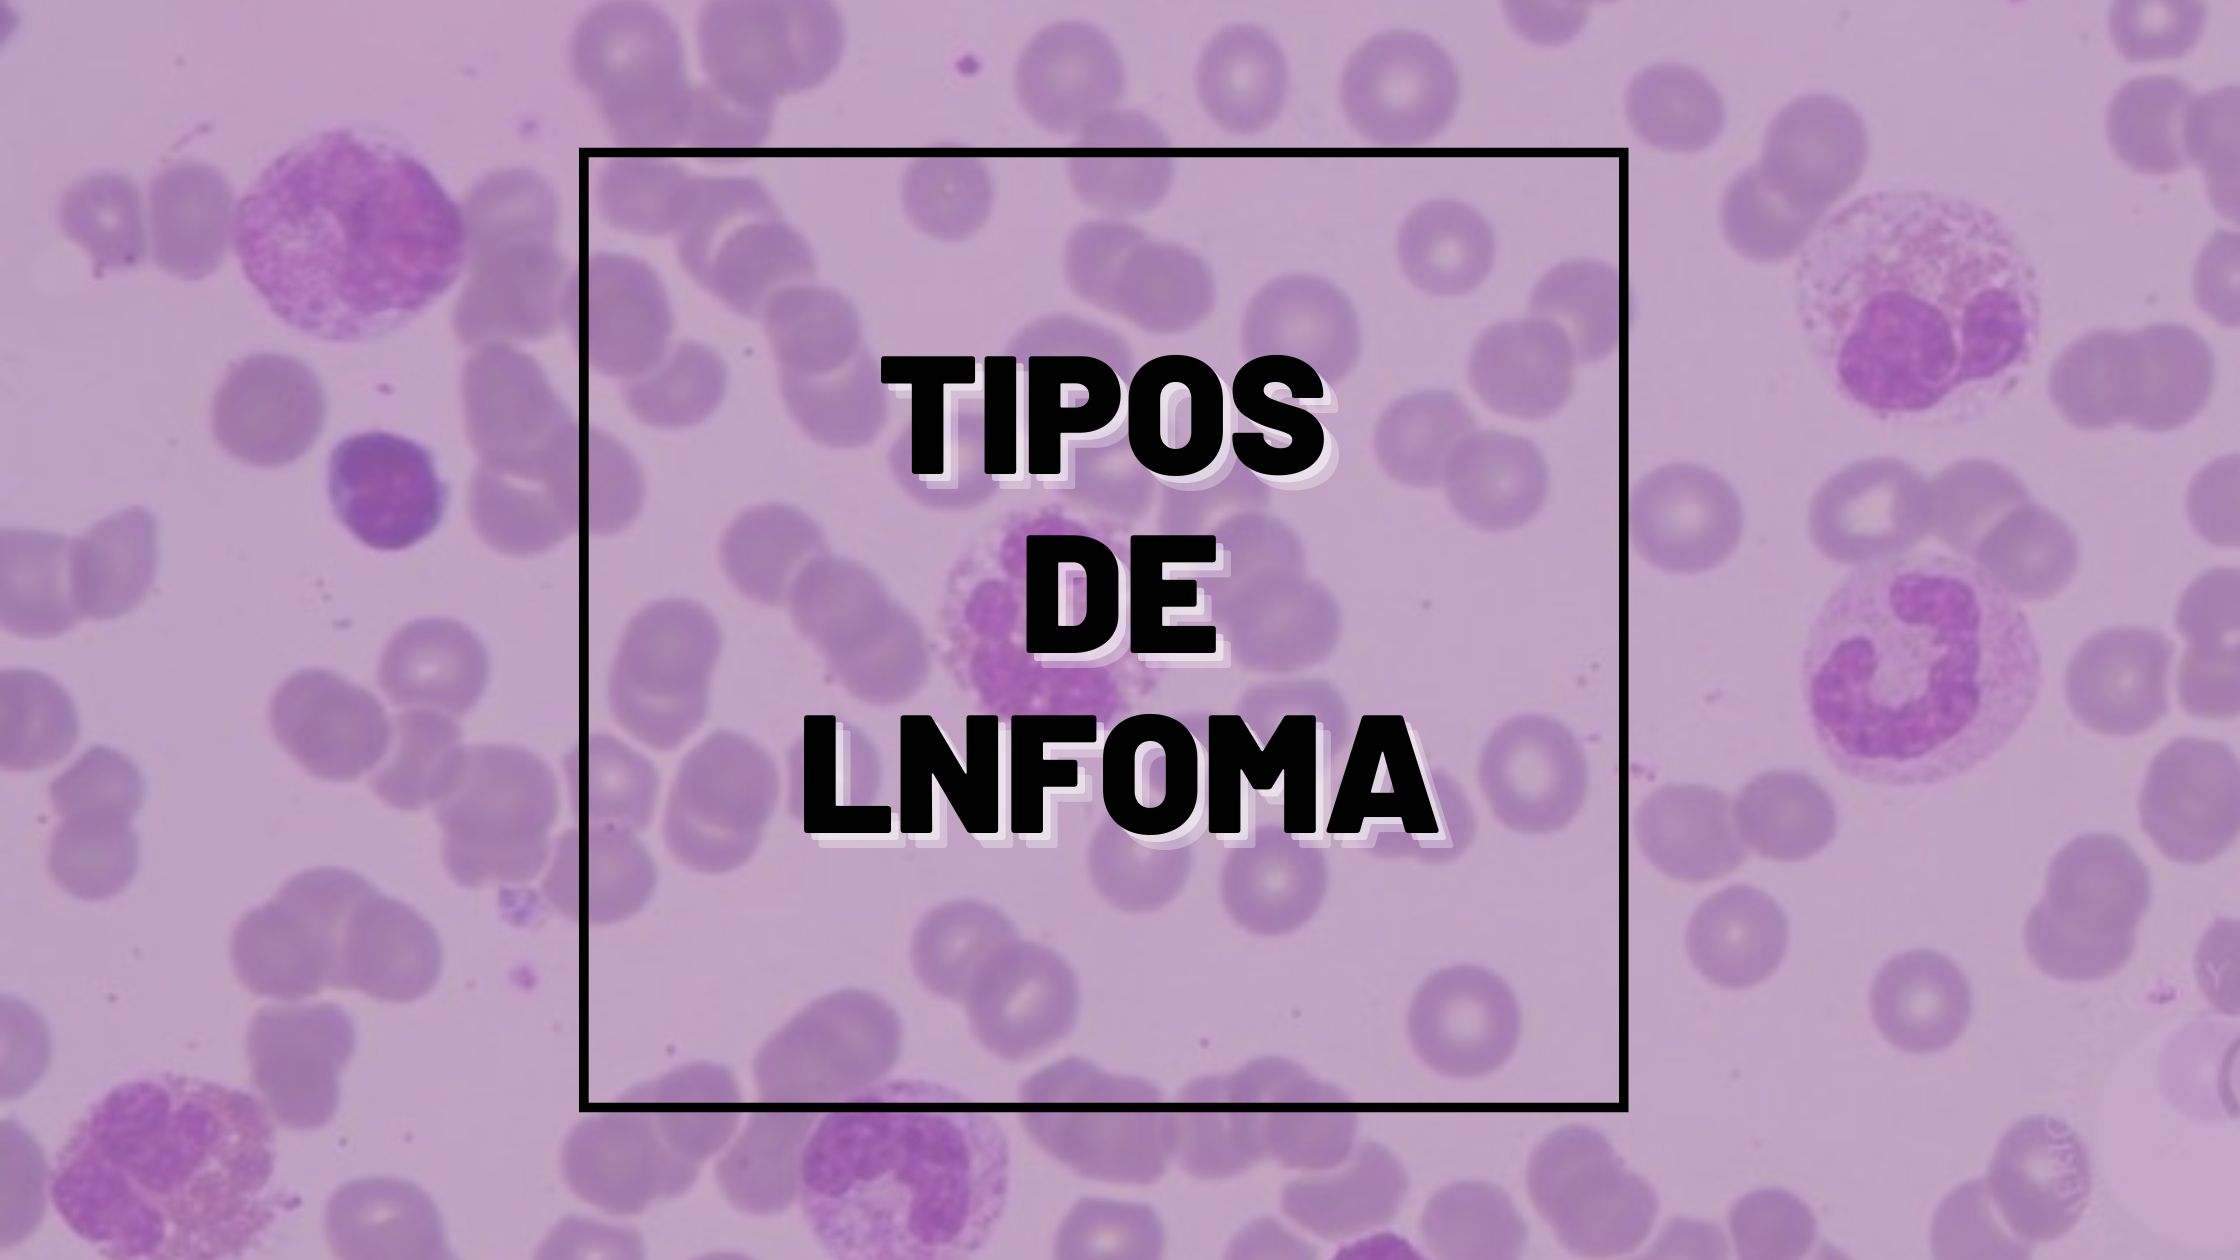

Quais são so tipos de linfoma: Hodgkin e não Hodgkin. Os linfomas são neoplasias malignas que se originam nas células do sistema linfático, principalmente nos linfócitos. O sistema linfático é uma parte essencial do sistema imunológico e inclui linfonodos (gânglios), baço, timo, medula óssea e vasos linfáticos.
Quando ocorre uma transformação maligna nessas células, elas passam a se multiplicar de forma descontrolada, formando tumores nos linfonodos ou em outros órgãos.
De forma geral, os linfomas são divididos em dois grandes grupos:
- Linfoma de Hodgkin (LH)
- Linfoma Não Hodgkin (LNH)
Essa classificação baseia-se principalmente em características histopatológicas e imunofenotípicas das células tumorais. O linfoma não Hodgkin é mais frequente, representando cerca de 80% dos casos de linfoma, enquanto o linfoma de Hodgkin corresponde a uma parcela menor, porém com altas taxas de cura quando diagnosticado precocemente.
Neste artigo completo, você entenderá:
- O que são os linfomas
- Diferença entre linfoma de Hodgkin e não Hodgkin
- Principais tipos de cada grupo
- Sintomas clínicos
- Achados laboratoriais
- Métodos diagnósticos
- Tratamento e prognóstico
O que é Linfoma?
O linfoma é um tipo de câncer hematológico que surge quando linfócitos sofrem mutações genéticas e passam a proliferar de maneira descontrolada. Essas células anormais podem se acumular nos linfonodos, medula óssea, sangue ou outros órgãos.
Diferente de leucemias, que se originam principalmente na medula óssea e no sangue periférico, os linfomas costumam surgir inicialmente nos linfonodos ou tecidos linfáticos.
Os linfomas podem afetar pessoas de qualquer idade, embora alguns subtipos tenham maior incidência em determinadas faixas etárias.
Qual a Diferença entre Linfoma de Hodgkin e Linfoma Não Hodgkin
A principal diferença entre esses dois grupos está na presença de um tipo celular específico observado na microscopia:
Linfoma de Hodgkin
Caracteriza-se pela presença das células de Reed-Sternberg, células gigantes multinucleadas derivadas de linfócitos B.
Características gerais:
- Disseminação geralmente ordenada entre cadeias linfonodais
- Maior incidência em adultos jovens
- Alta taxa de cura com tratamento adequado
Linfoma Não Hodgkin
É um grupo muito mais heterogêneo de neoplasias linfoides.
Características principais:
- Mais de 80 subtipos diferentes
- Origem em linfócitos B, T ou NK
- Pode apresentar crescimento indolente ou agressivo
- Disseminação frequentemente não linear pelo organismo
Tipos de Linfoma de Hodgkin
O linfoma de Hodgkin possui dois grandes grupos:
- Linfoma de Hodgkin clássico
- Linfoma de Hodgkin nodular com predominância linfocítica
1. Linfoma de Hodgkin clássico
Representa cerca de 95% dos casos.
Subtipos principais:
Esclerose Nodular
É o subtipo mais comum.
Características:
- Mais frequente em adultos jovens
- Linfonodos mediastinais frequentemente acometidos
- Presença de bandas fibrosas no linfonodo
Sintomas comuns:
- Massa mediastinal
- Tosse
- Dispneia
- linfadenomegalia cervical
Celularidade Mista
Características:
- Mais comum em homens
- Associado a infecção pelo vírus Epstein-Barr
- Mais frequente em países em desenvolvimento
Rico em Linfócitos
Características:
- Menor agressividade
- Melhor prognóstico
- Predomínio de linfócitos reativos
Depleção Linfocitária
Subtipo mais raro.
Características:
- Forma mais agressiva
- Associado à imunossupressão
- Pode ocorrer em pacientes com HIV
2. Linfoma de Hodgkin Nodular com Predominância Linfocítica

É um subtipo raro.
Características:
- Crescimento lento
- Melhor prognóstico
- Presença de células chamadas “popcorn cells”.
Tipos de Linfoma Não Hodgkin
O linfoma não Hodgkin é muito mais complexo, podendo ser dividido de diversas formas.
A classificação mais utilizada considera:
- Tipo celular
- Comportamento clínico
- Características moleculares
Existem mais de 80 subtipos de linfoma não Hodgkin, podendo ser classificados como indolentes ou agressivos.
Classificação dos Linfomas Não Hodgkin
Linfomas Indolentes
São de crescimento lento.
Exemplos:
Linfoma Folicular
- Segundo tipo mais comum
- Origem em linfócitos B
- Crescimento lento
Características:
- Linfadenomegalia indolor
- Curso clínico prolongado
- Pode permanecer assintomático por anos
Linfoma da Zona Marginal
Subtipos:
- MALT
- Esplênico
- Nodal
Associado frequentemente a infecções crônicas como Helicobacter pylori.
Linfoma Linfocítico de Pequenas Células
Muito semelhante à leucemia linfocítica crônica.
Linfomas Agressivos
Possuem crescimento rápido, porém maior potencial de cura.
Linfoma Difuso de Grandes Células B
- Tipo mais comum de LNH agressivo
- Representa cerca de 40% dos casos
Características:
- Crescimento rápido
- Linfonodos aumentados
- Pode acometer órgãos extralinfonodais
Linfoma de Burkitt
Um dos tumores de crescimento mais rápido.
Subtipos:
- Endêmico
- Esporádico
- Associado à imunodeficiência
Linfoma de Células do Manto
Características:
- Curso clínico agressivo
- Associado à mutação t(11;14)
Linfoma de Células T
Grupo heterogêneo de neoplasias derivadas de linfócitos T.
Sintomas Clínicos dos Linfomas
Os sintomas podem variar dependendo do subtipo e da extensão da doença.
Os mais comuns incluem:
Linfadenomegalia
Aumento dos linfonodos, geralmente:
- Cervicais
- Axilares
- Inguinais
Normalmente indolor.
Sintomas B
Os chamados sintomas B são importantes indicadores prognósticos.
Incluem:
- Febre inexplicada
- Sudorese noturna
- Perda de peso >10% em 6 meses
Outros sintomas
Podem incluir:
- Cansaço intenso
- Prurido
- Dor abdominal
- Tosse ou dispneia
- sensação de plenitude abdominal
Esses sintomas ocorrem devido ao aumento de linfonodos ou infiltração de órgãos.
Exames Laboratoriais nos Linfomas
Os exames laboratoriais são fundamentais tanto para suspeita quanto para acompanhamento da doença.
Hemograma
O hemograma pode apresentar alterações como:
- Anemia
- Leucocitose ou leucopenia
- Linfocitose ou linfopenia
- Trombocitopenia
Essas alterações ocorrem principalmente quando há infiltração da medula óssea.
VHS e PCR
Frequentemente aumentados devido ao processo inflamatório sistêmico.
LDH (Lactato desidrogenase)
Marcador importante.
Elevações indicam:
- alta atividade tumoral
- maior agressividade da doença
Beta-2 microglobulina
Marcador prognóstico utilizado em alguns tipos de linfoma.
Diagnóstico do Linfoma
O diagnóstico definitivo não é feito apenas por exames laboratoriais.
O exame essencial é a biópsia do linfonodo.
Essa biópsia permite:
- confirmação do diagnóstico
- classificação do subtipo
- avaliação imunohistoquímica
A aspiração simples não costuma ser suficiente para o diagnóstico.
Exames Complementares
Para estadiamento e avaliação da extensão da doença são utilizados:
Exames de imagem
- Tomografia computadorizada
- PET-CT
- Ressonância magnética
Biópsia de Medula Óssea
Avalia infiltração medular.
Imunofenotipagem
Identifica marcadores celulares como:
- CD20
- CD3
- CD15
- CD30
Estadiamento dos Linfomas
O sistema mais utilizado é o estadiamento de Ann Arbor.
Estágios:
Estágio I
Apenas um grupo de linfonodos.
Estágio II
Dois ou mais grupos no mesmo lado do diafragma.
Estágio III
Linfonodos em ambos os lados do diafragma.
Estágio IV
Doença disseminada com envolvimento de órgãos.
Tratamento dos Linfomas
O tratamento depende de diversos fatores:
- tipo de linfoma
- estágio da doença
- idade do paciente
- estado geral de saúde
As opções incluem:
Quimioterapia
É o tratamento mais utilizado.
Regimes comuns incluem:
- ABVD (Hodgkin)
- CHOP (não Hodgkin)
A quimioterapia destrói células tumorais de rápida divisão.
Imunoterapia
Utiliza anticorpos monoclonais, como:
- rituximabe (anti-CD20)
Esses medicamentos estimulam o sistema imune a destruir células tumorais.
Radioterapia
Pode ser utilizada em:
- doença localizada
- tratamento complementar
Transplante de Medula Óssea
Indicado principalmente em:
- recaídas
- doença refratária
O transplante utiliza células-tronco hematopoéticas para restaurar a medula óssea após altas doses de quimioterapia.
Terapias modernas
Tratamentos mais recentes incluem:
- Terapia CAR-T
- Terapias alvo-moleculares
- Imunoterapia avançada
Essas abordagens vêm mostrando resultados promissores em casos resistentes.
Prognóstico dos Linfomas
O prognóstico varia bastante entre os subtipos.
Fatores importantes incluem:
- tipo histológico
- estágio
- idade
- níveis de LDH
- resposta ao tratamento
De forma geral:
- Linfoma de Hodgkin possui altas taxas de cura
- Alguns linfomas agressivos também podem ser curados
- Linfomas indolentes costumam ter evolução prolongada, mas recaídas são comuns.
Conclusão Quais são os tipos de Linfoma de Hodgkin e não Hodkgin
Os linfomas são um grupo complexo de neoplasias hematológicas que se originam nos linfócitos e podem afetar diversos órgãos do sistema linfático. A divisão entre linfoma de Hodgkin e linfoma não Hodgkin é fundamental para compreender a biologia da doença, os tipos existentes e as estratégias terapêuticas.
Enquanto o linfoma de Hodgkin apresenta características histológicas específicas e geralmente uma disseminação mais previsível, os linfomas não Hodgkin constituem um grupo extremamente heterogêneo com dezenas de subtipos e comportamentos clínicos distintos.
O diagnóstico depende principalmente da biópsia do linfonodo, associada a exames laboratoriais e de imagem para estadiamento. O tratamento pode incluir quimioterapia, imunoterapia, radioterapia e transplante de células-tronco, com novas terapias emergentes, ampliando as possibilidades terapêuticas.
Graças aos avanços da medicina, muitos linfomas hoje apresentam altas taxas de cura ou controle prolongado da doença, especialmente quando diagnosticados precocemente.
Assista também a aula completa:
Quais são os tipos de Linfoma de Hodgkin e não Hodgkin
Sobre o Autor

0 Comentários